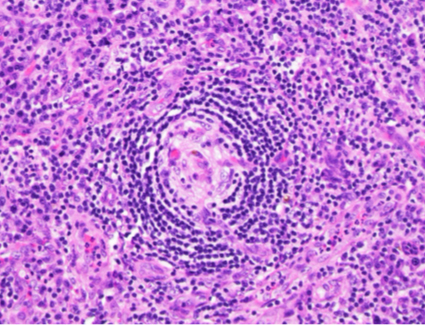

November Case 2021
Clinical History
A 49-year-old man presented with abdominal pain that progressed to generalized edema, ascites, pleural effusion, and acute renal failure, with anemia and thrombocytopenia. He was started on hemodialysis and underwent renal biopsy, which showed thrombotic microangiopathy. An autoimmune work-up was initiated while he was treated with steroids and plasmapheresis due to concern for thrombotic thrombocytopenic purpura (ADAMTS13 found to be normal). The autoimmune work-up was negative. He then developed respiratory failure and was intubated. Further work-up demonstrated polymicrobial pneumonia, CMV viremia, and VRE bacteremia. He was treated with broad-spectrum antibiotics, antimycotics, and steroids. Imaging showed hepatosplenomegaly, minimal periaortic lymphadenopathy and slowly resolving pneumonia. After a prolonged hospital course, which included tracheostomy and ventilator dependence, he was weaned from the ventilator and from dialysis and discharged.
He was later re-admitted for progressive shortness of breath, pleuritic chest pain, and abdominal pain. Chest x-ray showed bibasilar pulmonary infiltrates. A chest CT angiogram ruled out a pulmonary embolism and identified a multiloculated pleural effusion. Blood and pleural fluid cultures were obtained, and empiric antibiotic therapy was initiated for presumed community acquired pneumonia. Imaging also showed a new mediastinal mass with prominent adjacent lymph nodes, numerous prominent bilateral axillary lymph nodes, and splenomegaly was identified. Laboratory testing showed: WBC 14k cells/μL, Hgb 13g/dL, Plt 145k/μL, Cr 1.3mg/dL. Cultures were followed and found to be negative.
His respiratory symptoms improved with antibiotic therapy. However, imaging findings were concerning for an underlying lymphoproliferative disorder. A CT-guided biopsy of the mediastinal mass was non-diagnostic. A bone marrow biopsy showed a hypercellular marrow with severe myelofibrosis and no significant dysplasia or increase in blasts; JAK2, CALR, and MPL testing was negative. He then developed acute renal failure with markedly increased creatinine and potassium associated with worsening generalized edema. Repeat laboratory testing showed: WBC 9k cells/μL, Hgb 9g/dL, Plt 90k/μL, Cr 3mg/dL, IL-6 22pg/mL (normal range: 3-14pg/dL). HIV and HHV8 testing were negative.
Axillary lymph node biopsies were obtained.

H&E (40x magnification)

H&E (400x magnification)
H&E (400x magnification)

H&E (400x magnification)

Kappa

Lambda

IgG4

HHV8
The low power view shows lymph node tissue with abnormal follicles, including partial hyalinization, regression of germinal centers, and concentric mantle zone lymphocytes showing "onion skinning" appearance. Several follicles show prominent penetrating venules. No Hodgkin-Reed-Sternberg cells or LP cells were identified.
Immunohistochemical staining shows a polytypic plasmacytosis with no increase in IgG4+ plasma cells. HHV8 staining is negative.
Discussion of Diagnosis
TAFRO subtype of idiopathic Multicentric Castleman Disease (iMCD-TAFRO)
Multicentric Castleman Disease (MCD) encompasses three different clinical disorders: human herpes virus-8-associated MCD (HHV8-MCD); polyneuropathy, organomegaly, endocrinopathy, monoclonal plasma cell disorder, skin changes-associated MCD (POEMS-MCD), and idiopathic MCD, which is further subdivided into iMCD-not otherwise specified (iMCD-NOS), and iMCD-thrombocytopenia, ascites, reticulin fibrosis, renal dysfunction, organomegaly (iMCD-TAFRO) (1, 2).
Formalized diagnostic criteria for iMCD were first published in 2017 in an effort to improve accuracy in diagnosis, exclude the numerous clinical mimics, and to guide appropriate treatment (3). Historically, Castleman disease (CD) had been classified as unicentric (UCD) or multicentric (MCD) based on the number of involved lymph node stations and by its histopathologic features, namely "hyaline vascular" or "plasmacytic" variants. These histologic features, however, typically exist on a spectrum. "Hyaline vascular", now referred to as "hypervascular (HV)" type, is characterized by regressed germinal centers and prominent vascularization. Plasmacytic (PC) type features include hyperplastic germinal centers with prominent plasmacytosis. The intermediate "mixed" type shows features of both.
iMCD-TAFRO, as its name suggests, is a non-HHV8-associated type of MCD that presents with the clinical findings associated with the TAFRO acronym--Thrombocytopenia, Ascites, (reticulin) Fibrosis, Renal dysfunction, and Organomegaly. The F in TAFRO is sometimes said to indicate Fever (4). The histologic features are typically "mixed", as in the above case, but may instead show predominantly HV features. iMCD may also be associated with a polyclonal hypergammaglobulinemia, hypoalbuminemia, lymphocytic interstitial pneumonitis, and eruptive cherry angiomata or violaceous papules (1,3-5). iMCD-TAFRO presents on average in the 5th decade and is slightly more common in men than in women (1,4,5). The pathogenesis of iMCD is unclear but seems to involve IL-6, VEGF, and mTOR signaling (1). The clinical course is usually very aggressive.
In the case presented, the underlying pathology was initially obscured by a superimposed pneumonia; however, once the infection was treated, the TAFRO features became more apparent. Histologic evaluation of an enlarged lymph node showed characteristic histologic features, establishing the diagnosis of iMCD-TAFRO. In fact, histologic evaluation is still a major diagnostic criterion along with identifying multicentricity of enlarged lymph nodes. However, as these histologic features alone may be nonspecific, evaluation for minor diagnostic criteria and exclusion of other diagnoses, as demonstrated in this case, are necessary to make the definitive diagnosis. A systematic approach to exclude infectious, autoimmune and malignant etiologies is necessary. Additional pitfalls could include Hodgkin lymphoma (classic or nodular lymphocyte predominant), plasma cell neoplasms, and IgG4-related disease, which were excluded in this case. The reader is guided to this reference for specific diagnostic criteria.
The patient received anti-IL-6 therapy (siltuximab) with high dose steroids, resulting in rapid clinical improvement. The following treatment algorithm shows the consensus guidelines for the treatment of iMCD (1,7).

References
- Dispenzieri A, Fajgenbaum DC. Overview of Castleman disease. Blood. 2020 Apr 16;135(16):1353-1364. doi: 10.1182/blood.2019000931. PMID: 32106302.
- Swerdlow, SH., Campo, E et al. WHO Classification of Tumours of Haematopoietic and Lymphoid Tissues (Revised 4th Edition). IARC: Lyon 2017.
- Fajgenbaum DC, Uldrick TS, Bagg A, Frank D, Wu D, Srkalovic G, Simpson D, Liu AY, Menke D, Chandrakasan S, Lechowicz MJ, Wong RS, Pierson S, Paessler M, Rossi JF, Ide M, Ruth J, Croglio M, Suarez A, Krymskaya V, Chadburn A, Colleoni G, Nasta S, Jayanthan R, Nabel CS, Casper C, Dispenzieri A, Fosså A, Kelleher D, Kurzrock R, Voorhees P, Dogan A, Yoshizaki K, van Rhee F, Oksenhendler E, Jaffe ES, Elenitoba-Johnson KS, Lim MS. International, evidence-based consensus diagnostic criteria for HHV-8-negative/idiopathic multicentric Castleman disease. Blood. 2017 Mar 23;129(12):1646-1657. doi: 10.1182/blood-2016-10-746933. Epub 2017 Jan 13. PMID: 28087540; PMCID: PMC5364342.
- Iwaki N, Fajgenbaum DC, Nabel CS, Gion Y, Kondo E, Kawano M, Masunari T, Yoshida I, Moro H, Nikkuni K, Takai K, Matsue K, Kurosawa M, Hagihara M, Saito A, Okamoto M, Yokota K, Hiraiwa S, Nakamura N, Nakao S, Yoshino T, Sato Y. Clinicopathologic analysis of TAFRO syndrome demonstrates a distinct subtype of HHV-8-negative multicentric Castleman disease. Am J Hematol. 2016 Feb;91(2):220-6. doi: 10.1002/ajh.24242. PMID: 26805758.
- Fujimoto S, Sakai T, Kawabata H, Kurose N, Yamada S, Takai K, Aoki S, Kuroda J, Ide M, Setoguchi K, Tsukamoto N, Iwao-Kawanami H, Kawanami T, Mizuta S, Fukushima T, Masaki Y. Is TAFRO syndrome a subtype of idiopathic multicentric Castleman disease? Am J Hematol. 2019 Sep;94(9):975-983. doi: 10.1002/ajh.25554. Epub 2019 Jun 21. PMID: 31222819.
- Fajgenbaum DC, Langan RA, Japp AS, Partridge HL, Pierson SK, Singh A, Arenas DJ, Ruth JR, Nabel CS, Stone K, Okumura M, Schwarer A, Jose FF, Hamerschlak N, Wertheim GB, Jordan MB, Cohen AD, Krymskaya V, Rubenstein A, Betts MR, Kambayashi T, van Rhee F, Uldrick TS. Identifying and targeting pathogenic PI3K/AKT/mTOR signaling in IL-6-blockade-refractory idiopathic multicentric Castleman disease. J Clin Invest. 2019 Aug 13;129(10):4451-4463. doi: 10.1172/JCI126091. PMID: 31408438; PMCID: PMC6763254.
- Van Rhee F, Voorhees P, Dispenzieri A, Fosså A, Srkalovic G, Ide M, Munshi N, Schey S, Streetly M, Pierson SK, Partridge HL, Mukherjee S, Shilling D, Stone K, Greenway A, Ruth J, Lechowicz MJ, Chandrakasan S, Jayanthan R, Jaffe ES, Leitch H, Pemmaraju N, Chadburn A, Lim MS, Elenitoba-Johnson KS, Krymskaya V, Goodman A, Hoffmann C, Zinzani PL, Ferrero S, Terriou L, Sato Y, Simpson D, Wong R, Rossi JF, Nasta S, Yoshizaki K, Kurzrock R, Uldrick TS, Casper C, Oksenhendler E, Fajgenbaum DC. International, evidence-based consensus treatment guidelines for idiopathic multicentric Castleman disease. Blood. 2018 Nov 15;132(20):2115-2124. doi: 10.1182/blood-2018-07-862334. Epub 2018 Sep 4. PMID: 30181172; PMCID: PMC6238190.